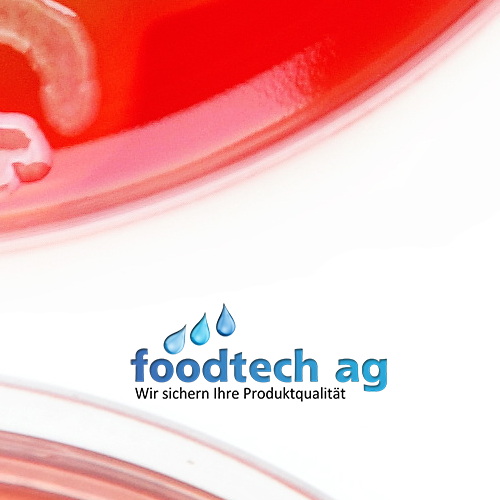

5 ppt NaCl Calibration 480ml
Artikelnummer ECNACL5PPT
5 ppt NaCl Calibration Solution
{"article_attributes":[],"prepared_stocks":{"out":0,"low":0,"min_qty":0,"max_qty":9223372036854775807,"allow_buy_out_of_stock":true},"extended_prices":[{"currency":"CHF","precision":2,"is_excluded":true,"gross":{"normal":97.29,"discounted":null},"net":{"normal":"90.00000","discounted":null},"vat_percent":"8.10","tax_included":0,"discount_type":null}],"images":[{"imageable_ids":"0","imageable_types":"","id":1524,"article_id":254,"is_external":0,"file_id":166,"external_url":null,"name":"fte.jpg","active":1,"cover":0,"position":0,"imageable_id":0,"imageable_type":"","alt":"FTE","ts":"2024-08-12 08:40:41","createtime":"2024-08-12 08:40:36","s3_url":"http:\/\/10.0.236.86:9000\/wbs.company.55505733\/161\/fte.jpg"}],"available_policies":[],"wbsHost":"\/\/foodtech.ch\/wbs","wbsCompanyId":55505733}